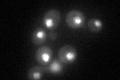
YOR207C
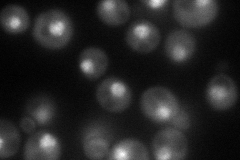
YOR207C

View description
Second-largest subunit of RNA polymerase III, which is responsible for the transcription of tRNA and 5S RNA genes, and other low molecular weight RNAs
Localization:
Intensity:
Fold change:
Significance:
-
C’ GFP library in SD
nucleus60.79 -
N' NOP1pr-GFP in SD
cytosol,nucleus73.197 -
N' TEF2pr-mCherry in SD

punctate,nucleus59.564 -
N' NATIVEpr-GFP in SD

punctate,nucleus59.4362 -
N' TEF2pr-VC and Cyto-VN in SD

punctate,nucleus31.8044 -
C’ GFP library in SD+DTT

nucleus45.460.74No -
C’ GFP library in SD+H2O2

nucleus53.60.88No -
C’ GFP library in Starvation Media

nucleus36.060.59Yes -
C’ GFP library on the background of Pup2-DaMP

nucleus -
C’ GFP library on the background of CCT mutant

nucleus66.97771.10171No
